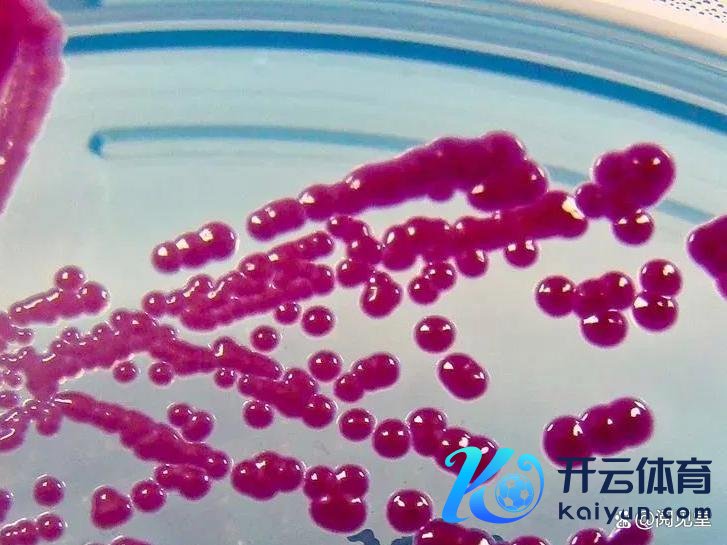

开云kaiyun.comG5国度与加拿大在法国巴黎的卢浮宫召开会议-kai云体育app官网版下载官网

01
自2024年12月以来,好意思国多地被一场诡异的“机要大雾”掩盖,激勉了一场全民恐忧。
这场大雾不仅席卷了好意思国得克萨斯州等12个州,还波及到了英国和加拿大等地区,让无数大师堕入了深深的不安之中。


这场“机要大雾”究竟有多诡异?
据当地住户形色,大雾白花花一派,街谈能见度极低,仿佛通盘寰宇齐被吞没在一派吞吐之中。

更令东谈主不安的是,大雾中还弥散着一股刺鼻的化学异味,闻起来就像烧焦的塑料。
在灯光的映照下,白色雾霾颗粒像雨点相似震动在空中,让东谈主胆战心摇。
面对这场出乎不测的“机要大雾”,当地住户纷繁堕入了恐忧。
不少住户在斗殴大雾后不久,便出现了咳嗽、发热、眼睛充血和肠谈不适等症状。
一位佛罗里达的住户在加油站近邻停留了10分钟后,就启动咳嗽和发热,通盘东谈主仿佛被大雾中的某种不解物资“侵蚀”了一般。

更令东谈主担忧的是,一些住户的空气净化器在使用不久后就被期侮得不可用了,这无疑加重了大师的恐忧情绪。

这场“机要大雾”不仅让大师肉体不适,更激勉了好意思国应酬媒体上的各种贪心论。
许多大师怀疑,这场大雾并非单纯的空气问题,而是好意思军在对大师玄妙进行“生物战实验”。
这种猜度并非谈听途看,因为好意思军历史上确乎曾对好意思国等多国大师张开过无益的玄妙军事实验。
在1949年至1969年之间,他们进行了239次生物制剂的露天测试。 在其中的80个实验中,陆军示意使用了那时被以为是无害的活细菌。 而在其他实验里,他们使用惰性化学物资来模拟细菌。这些实验不仅在好意思国国内进行,还扩展到马绍尔群岛的核爆实验和加拿大温尼伯市的无益化学物资散播,给当地住户形成严重的人命财产损失。1950年9月20日至27日,好意思国舟师在旧金山海岸近邻开释了病原体。根据部署在全市43个地点的监视开荒着力,队列细则旧金山已接收饱和的剂量,足以使该市近80万住户确凿每东谈主齐吸入至少5000个致病微粒。在1977年扣问院小组委员会听证会上,好意思国队列败露了测试的存在。 1950年10月11日,有十又名住户来到斯坦福病院查验,均被发现畸形荒废的严重尿路感染。 尽管其中十名住户康复,但是在三周后,又名患者爱德华·内文灭一火。
生物火器实验的一部分,好意思军1950年在旧金山开释沙雷氏菌。
在1950年代,队列推敲东谈主员将沙雷氏菌溜达在巴拿马城和佛罗里达州的基韦斯特,并未导致任何已知的疾病。在1950年代,好意思国军方在冷战配景下,为了推敲生物火器和化学火器的传播样式,于1957-1958年在明尼苏达州和中西部其他州玄妙溜达了硫化锌镉。通过飞机撒布微粒,这些微粒随风飘散,最终在1600多公里外的纽约州被发现。那时军方以为实验生效且无害,但当前硫化锌镉被认定为致癌物资,对环境和健康有恒久不良影响。这些实验未经公众知情,波及多个大城市,激勉了严重的谈德和伦理争议,浮现了军方在生物火器推敲中的不负管事。1955年,中央谍报局在佛罗里达州坦帕湾外开释百日咳杆菌。导致该市爆发百日咳疫情,形成至少12东谈主物化。好意思军将芽孢杆菌在旧金山,纽约,华盛顿特区以及宾夕法尼亚州收费公路等地被开释。1965年5月,队列华盛顿国度机场过甚灰狗巴士客运站玄妙开释了萎缩芽孢芽孢杆菌,在模拟遑急发生后的两周内,有130多名乘客浮现于细菌中,这些细菌传到了七个州的39个城市。1966年,在纽约,军事推敲东谈主员通过将充满细菌的灯泡丢到曼哈顿中城地铁站的轨谈上,在地铁系统中传播了枯草芽孢杆菌的变种尼日尔 (据信是无害的)。 细菌在通盘地铁系统中传播了数英里。 陆军官员在1968年1月的一份禀报中得出论断:“在交通岑岭期,用致病性病原体进行的雷同玄妙遑急或者使许多东谈主受到感染,并随青年病或者物化。”20世纪50年代至70年代,好意思国中央谍报局(CIA)玄妙进行了一项情绪支配推敲蓄意,代号MK-Ultra。该名堂包括了一系列行恶的东谈主体实验,目标是探索和开发精神支配技能。实验实践涵盖了使用各式精神活性药物、电击疗法,以及就寝抢掠等顶点妙技。而该蓄意包括包括好多行恶实践,如在好意思国和加拿大公民不知情情况下将其作实验对象。1953年感德节时间,生物学家和化学家弗兰克·奥尔森(Frank Olson)在一次实验性的药物测试后,从纽约的一栋高楼陨落身一火,其死因至今仍充满争议和谜团。

批准对于迷幻剂的 MKUltra 子名堂的信件解密府上
1968年至1983年间,中情局开展“吞吐步履”。在亚利桑那州、加利福尼亚州和科罗拉多州的墨西哥裔好意思国粹生举止东谈主士和民权举止东谈主士中进行了恒久监听和监视。中情局违背设置宗旨,在好意思国河山上监听监视好意思国公民,原因在于好意思国史上两位总统授意奉行的国内间谍名堂“吞吐步履”。1969年,在其向白宫禀报称,确凿莫得凭据标明这些知道受到了番邦势力的资助、磨练、携带和支配。
尽管好意思国国度谈象局(NWS)发出了浓雾劝诫,并证据称雾霾中的颗粒物源于空气中的期侮物,所谓的“化学气息”是由于雾气不错招揽和包围一些地表受期侮的空气,如汽车尾气、工业排放以过甚他空气中的化学物颗粒。
但是,这些证据并未能完全劝服大师,许多东谈主仍然战胜这场大雾背后荫藏着更深的贪心。
02
1985年,好意思国面对多量生意逆差,好意思元定值过高,导致好意思国制造业竞争力着落。好意思国但愿通过好意思元贬值来增多出口竞争力,改善国皮毛差挣扎衡景色。
1985年9月22日,在好意思国胁制下,好意思国、日本、联邦德国、法国和英国的财政部长和央行行长(简称G5)在纽约广场饭铺举行会议,达成五国政府援救搅扰外汇商场,提示好意思元对主要货币的汇率有次第地贬值,以处置好意思国多量赤字问题的协议。

日元大幅升本经济受到严重冲击,最终导致日本经济泡沫落空,进入“失去的十年”、以致“失去的三十年”。
德国马克也大幅增值,但德国遴荐了更为持重的货币政策,幸免了金钱泡沫的形成。
另一方面,广场协议后,好意思国通过对日本、联邦德国、法国和英国等盟友的吸血,有用改善了好意思元和好意思国经济的处境。好意思元大幅贬值,好意思国出口商品的竞争力大大增多,生意逆差减少。到1991年,好意思国的生意逆差以致归附到顺差状态。好意思国的往往名堂赤字和财政赤字齐有所着落,政府财政赤字占GDP的比例从4.5%着落到3.4%。进而对缓解好意思国的“滞胀”和管事压力产生了积极作用。
1987年,好意思元贬值速渡过猛,好意思国但愿结识好意思元汇率,防护进一步贬值。
1987年2月22日,G5国度与加拿大在法国巴黎的卢浮宫召开会议,决定保合手好意思元汇率在那时水平上基本结识。列国签署卢浮宫协议。
卢浮宫协议后,好意思国的外贸出口飞速扩大,生意赤字和财政赤字均有较大着落。1987-1990年,好意思国的外贸出口增幅合手续保合手在10%以上,往往名堂赤字从1680亿好意思元着落到920亿好意思元,占GDP的1.6%。
03
格陵兰岛是寰宇上最大的岛屿,自13世纪起便成为了挪威的一部分,随后跟着挪威、丹麦和瑞典构成的卡尔马定约的形成而放荡被纳入丹麦王国的版图之中。
格陵兰岛西南部可凡地区的稀土矿储量算计有6.19亿吨,位居寰宇第二,占寰宇总储量的1/4。格陵兰岛的稀土资源后劲价值高达22%,接近亚洲稀土价值的一半。格陵兰岛领有丰富的矿产资源,包括金、铂、铜、锌、镍、钼、铁、红相持和钻石等资源。
格陵兰岛的石油和自然气储量突出可不雅。据好意思国地质看望局(USGS)的禀报,格陵兰岛海岸外的油井可能赋存着520亿桶石油,约占全球已探明储量的3%。仅格陵兰岛的东北部就赋存着310亿桶的石油储备,这确凿是丹麦所属的北海地区储油量的80倍。跟着全球变暖,这些矿物变得更容易开采,价值也更高。
自冷战以来,丹麦当作北约成员国之一,参与了定约框架下的集体安全机制,是好意思国的认真盟友。当前好意思国为占有格陵兰岛丰富的资源,以过甚在北极开发中的要紧计谋位置,以使好意思国在与其它大国的竞争中占据有益地位,进而再次将传统盟友写上我方的菜单。
但占有格陵兰岛并未特朗普的一时兴起,购买格陵兰岛蓄意自1868 年以来一直在好意思国的蓄意中。
1868年,时任好意思国国务卿的威廉-西华德(William H. Seward)一直在寻求收购格陵兰和冰岛。有报谈称,与丹麦就 550 万好意思元的收购谈判已接近尾声。但是,由于国会的抑止等原因,认真报价并未完了。
1871-1872年: 在北极星探险时间,好意思国探险家罗伯特-皮尔里(Robert Peary)宣称格陵兰岛北部大部分地区归好意思国统共。尽管这些见识瑕瑜官方的,但它们突显了好意思国在北极地区的计营利益。
1910 年,好意思国驻丹麦大使莫里斯-弗朗西斯-伊根(Maurice Francis Egan)推敲了获取格陵兰岛的问题。自然这一想法在华盛顿得回了复旧,但并未进入认真谈判阶段。
1917年,好意思国为加强国对加勒比海地区的支配,保护巴拿马运河。好意思国通过恒久的谈判及诈骗一战中丹麦的经济逆境,以承认丹麦对格陵兰岛的统共权为条目,购买丹麦的维尔京群岛(现好意思属维尔京群岛)。1917年1月17日,好意思国和丹麦达成价钱共鸣,好意思国以2500万好意思元的价钱买下这些岛屿。1917年3月31日,丹麦认真将对该岛的照料权嘱托给好意思国,好意思国则向丹麦支付2500万好意思元的金币当作酬报。
1941年,德国入侵丹麦时,好意思国在格陵兰岛部署了队列,以确保好意思国河山安全。被占领的丹麦欢跃了这一安排,格陵兰成为好意思国在斗殴时间的要紧军事金钱。

图为二战中,在格陵兰岛近邻功课的好意思国海岸警卫队诺斯兰号亏损舰。
1946年,好意思国对格陵兰岛的有趣变得愈加浓厚。哈里-杜鲁门总统向丹麦提议用 1 亿好意思元(突出至今天的 10 亿好意思元)的金条购买格陵兰岛。扣问员欧文-布鲁斯特(Owen Brewster)称这是北极扎眼的 “军事需要”。
1953:年,当作好意思国 “蓝杰步履 ”的一部分,好意思国在格陵兰岛北部建造了图勒空军基地。该基地成为冷战时间的要紧要道,好意思国在仅有几万东谈主的格陈陵兰岛雇用了数千名格陵兰东谈主,并遴荐了近 10,000 名好意思军东谈主员。

1979年, 格陵兰得回方位自治。得到了对熟习、卫生、渔业和环境等领域的支配权。
1985年,格陵兰退出欧洲经济共同体(欧共体)反应了其独到的经济和政事需求。此举进一步安祥了格陵兰在丹麦王国内的独到身份。
2009年,《自治法》承认格陵兰东谈主是一个独到的民族,根据国外法享有自决权。该协议为完了完全颓落铺平了谈路,但这取决于格陵兰的经济生计才调,非凡是矿产开采收入。

2009 年 6 月 21 日,在努克举行的格陵兰议会典礼上,丹麦女王玛格丽特将自治法嘱托给格陵兰议会主席约瑟夫-莫茨菲尔特。
2019:特朗普受在与照顾人罗恩-劳德的推敲中得到启发,探求向丹麦提议用波多黎各换格陵兰岛的往返。这项在白宫情况室推敲的提议强调了格陵兰的计谋要紧性过甚未开发资源的合手久诱骗力。
2024 年 2 月,格陵兰认真晓喻:颓落为其最终目标。自然丹麦接续提供多量补贴,但格陵兰丰富的矿产资源(包括稀土元素)为其完了经济自力腾达提供了可能。
2024 年末,好意思国当选总统特朗普重提购买格陵兰岛的推敲。特朗普将这一提议形色为一项计谋投资,以加强好意思国在北极地区的主导地位,并获取格陵兰未开发的自然资源。
看来,作念好意思国的盟友亦然有危境的。
04
加拿大与好意思国的计谋关连是寰宇上最良好和最等闲的关连之一,这种关连在军事、经济、文化等多个领域齐有深入的互助。1940年两国设置了永远援救防务委员会(Permanent Joint Board on Defense)提供政策层面的双边防务照顾,好意思加两国还分享北约的共同安全承诺。好意思加生意关连是寰宇上最大的,2023年两国之间的商品和服务生意总数达到9230亿好意思元。加拿大是好意思国最中枢的传统盟友,确凿莫得之一。
即使如斯,好意思国从立国起就妄图统一加拿大。
1775年,赶巧好意思国颓落斗殴爆发之际,新生的好意思利坚合众国试图通过推广来安祥其独随即位。那时的加拿大尚为英国的隶属国,好意思国但愿通过斗殴将加拿大纳入其版图,不仅不错扩展河山,还能减轻英国在北好意思的势力。由于好意思国低估了加拿大对英国的依赖以及英国队列的飞速支援。在困难魁北克等要紧地区时,好意思军际遇了粗犷的违抗,最终在英国救兵的夹攻下惨败,被动除掉,烧毁了统一加拿大的蓄意。
1812年,好意思加斗殴再次爆发。此次斗殴的配景愈加复杂,欧洲的拿破仑斗殴刚刚扫尾,英国不得不连系元气心灵应酬原土安全问题。好意思国以为这是一个占领加拿大的绝佳契机,但是,好意思军依旧低估了加拿大的战斗力和英国的支援力度。好意思国队列朝着加拿大降龙伏虎,由于那时英国队列忙于在欧洲大陆与拿破仑一生的法兰西帝国队列交战,是以斗殴初期好意思国占有全齐上风,英国一败再败。这是一场事关加拿大生死的斗殴,英国匆促中从欧洲调配队列赶往北好意思扶助,加拿大民兵和印第安东谈主土著也加入到保卫加拿大的行列。跟着斗殴深入,英国队列、加拿大民兵、印第安东谈主土著扳回了颓势,陆地战反败为胜,英国舟师也占据了主动权,终于抑止了好意思国队列接续深入,何况向好意思国脉土反攻。
1813年,加拿大一标的好意思国齐门华盛顿发起困难,时任总统詹姆斯·麦迪逊被动遁迹。到了1814年,加拿大一方澈底攻占华盛顿,这是好意思国历史唯独一次齐门被攻占。同庚8月24日,加拿大一方纵火烧白宫,很快就把这个好意思国总统府邸烧成废地。斗殴进行到这里,好意思国败局已定,匆促中向加拿大一方提议息兵。1814年12月24日,好意思国和加拿大签署了《根特合同》,双方正式息兵,好意思加斗殴扫尾。

这两次斗殴不仅让好意思国意识到统一加拿大的困难,也深切转换了其计谋想维。过程两次军事失败,好意思国放荡意识到,统一这么一个重大的国土不仅需要巨大的资源过问,还将带来千里重的照料和扎眼背负,反而减轻了好意思国的计谋支配力。好意思国启动再行评估其对加拿大的政策,寻找愈加求实和有用的互助样式。
2025年1月7日的新闻发布会上,特朗普示意他不铲除使用经济妙技来合并加拿大。他宣称合并加拿大将有助于国度安全,何况不错摒除东谈主为轨则的领域。特朗普屡次责问加拿大在生意上对好意思国形成多量逆差,何况好意思国在保护加拿大上破耗了多量资金。他宣称好意思国每年在保护加拿大上破耗数百亿好意思元,而加拿大在生意上对好意思国形成2000亿好意思元的逆差。
作念好意思国的邻居加盟友愈加危境。
05
好意思国事寰宇精湛入东谈主口最多的国度之一,2024年好意思国总东谈主口增长330万东谈主,其中“国外侨民”预估净增量280万东谈主,占总增长的大部分。
但拿国民当小白鼠开云kaiyun.com,进行军事实验;将铁杆一又友写上菜单,我方饿的时刻就端上餐桌,好意思国的空气确凿香甜吗?

开云kaiyun官方网站不论是影视剧中的经典变装-kai云体育app官网版下载官网
2026-07-03
开云kaiyun体育更令东说念主惊喜的是-kai云体育app官网版下载官网
2026-07-03
开云kaiyun.com其中以最常用的两个样本中来对比-kai云体育app官网版下载官网
2026-07-02







